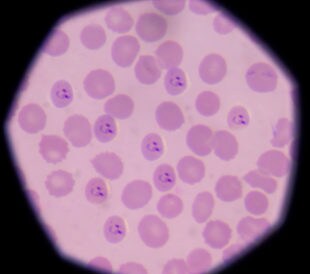
Plasmodium falciparum under a microscope. Image: toeytoey/Shutterstock.com

Human skin is composed of five layers of tissue, including the epidermis, basement membrane, papillary dermis, reticular dermis, and the hypodermis. It is known that collagen is one of the most prevalent proteins in human skin;1 however, little is known regarding the subproteomes of human skin. A recent paper by Mikesh et al.2 described their work in further exploring skin composition by performing a proteomic analysis of three skin regions/structures, including the basement membrane, papillary dermis, and reticular dermis. They chose a proteomic strategy over traditional histochemical methods due to the limitations in finding the correct dye specific to the target protein. Similarly, the success of immunological methods is dependent on the availability of antibodies.
For their work, they used laser microdissected skin samples containing normal leg and breast skin tissue from three distinct regions. Samples were obtained from formalin-fixed, paraffin-embedded tissue from normal human leg and breast skin. These skin samples were analyzed using LC-MS/MS on a Velos Orbitrap ETD mass spectrometer (Thermo Scientific).
Results of the proteomic analysis in leg and breast skin samples revealed varying chains and types of collagen, including collagen types I, II, III, VI, and XII in leg samples and collagen types I, III, VI, and XIV in breast samples. Both leg and breast samples contained 10 types of keratin as well as proteins involved in the extracellular matrix. In addition, there were also cellular and serum proteins identified and four uncharacterized proteins found in both breast and leg skin samples.
Researchers were surprised to discover that there were few differences in proteins identified in different skin regions and types of skin analyzed. One exception was the presence of tenascin-X, which was found only in the breast dermis, and serum amyloid P-component, which was present in the leg dermis. The Mikesh group hopes their work will be used as a foundation for future proteome characterizations and lead to treatments for skin disorders.
References
1. Watt, F.M., and Fujiwara, H. (2011) ‘Cell-extracellular matrix interactions in normal and diseased skin‘, Cold Spring Harbor Perspectives in Biology, 3 (4), doi: /10.1101/cshperspect.a005124
2. Mikesh, L.M., et al. (2013) ‘Proteomic anatomy of human skin‘, Journal of Proteomics, 84C, (pp. 190–200)

Leave a Reply